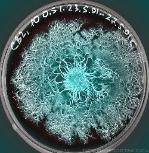

THE MANDELA EFFECT HELP GUIDE
| WE HAVE BEEN IN CONSTANT BATTLE AND WAR AND WE HAVE SOLUTIONS TO AID IN THE CURRENT ILLUSIONS OF THE MANDELA EFFECT CAST DOWN UPON THE EARTH AND HUMAN POPULATION. OUR RULE: IF IT IS NOT CLEAR HARD PHYSICAL EVIDENCE UTILIZING ALL FIVE SENSES UP FRONT AND IN PERSON AND IN REAL TIME, THEN IT IS MOST LIKELY INTENTIONAL OR UNINTENTIONAL DECEPTION. IF IT CONFUSES AND DON'T MAKE SENSE THEN IT IS DESIGNED TO TRICK AND ENTRAP YOUR MINDSET. WE ARE SINCERE AND WE ARE NOT ALONE! WE ARE GETTING HELP FROM OUTSIDE EARTH! THERE'S ABSOLUTELY NO MISTAKE ABOUT IT, THERE'S ABSOLUTELY AN ADVANCED CRYSTAL TECHNOLOGY WHICH SUPERSEDES ALL QUANTUM MATTER AND MACHINES AND IT IS THE PRIME SOURCE OF ALL REALITY RELATIVE TO EARTH DWELLERS. SOMEONE IS HURTING YOU PHYSICALLY, MENTALLY, EMOTIONALLY, SOCIALLY AND SPIRITUALLY AND THEY SEEK BAD RESULTS BY YOU. THIS IS NOT A JOKE OR A LIE, SOMEONE OUTSIDE EARTH, MOST LIKELY IN THAT CRYSTAL CITY IS CAUSING EARTH DWELLERS PHYSICAL, MENTAL, PSYCHOLOGICAL AND SOCIAL HARM AT THE UTMOST SERIOUS LEVEL POSSIBLE, EVEN TO THE EVENT OF MURDER AND GENOCIDE AND RUIN OF THE EARTH EXISTENCE AT THE FIRST DEGREE! WE MUST FIGHT EVEN IF IT MEANS FORCING OUR GOVERNMENTS TO ALLOW US TO THE EDGES OF THE EARTH, A PHYSICAL WAY OUT OF THIS EARTH DOME! WE ARE AT WAR ON ALL SIDES! WE FULLY UNDERSTAND THAT IF YOU REALLY DON'T KNOW WHERE YOU EXIST AND HOW YOU EXIST AND IF YOU DON'T REALLY KNOW THE ABSOLUTE PHYSICAL TRUTHS BY WHICH WE STAND, THEN MOST MATERIAL CONTAINED IN THIS DIALOGUE WILL SEEM MADE UP AND UNREAL. THIS MATRIX MUST BE CHALLENGED AND CHANGED FOR THE BENEFIT OF THOSE WHO ARE GOOD! DEAR READER, WE WILL ADDRESS STRAIGHT FORWARD WAYS FOR YOU TO DEAL WITH THE MANDELA EFFECT. THIS WEBSITE IS TO BE CONSIDERED SERIOUS UPON THE HIGHEST LEVEL OF INTEREST FOR EVERYONE INCLUDING THOSE WHO ARE NOT AFFECTED BY THE MANDELA EXPERIENCE. EVERYONE IS UNDER THE INFLUENCE OF THIS EFFECT! WE WILL ADDRESS KEY THINGS YOU MUST DO IN ORDER TO WITHSTAND THE EFFECTS OF THE MANDELA EARTH EXPERIENCE. WE WILL PROVIDE YOU KNOWLEDGE OF WHAT IS GOING ON AND HOW YOU CAN DO SOMETHING ABOUT IT. IF YOU SO DESIRE THEN SKIP DOWN TOWARDS THE BOTTOM OF THIS PAGE TO THE TITLE: "HERE ARE METHODS TO FIGHT THE ILLUSIONS" THE FOLLOWING WRITING IS TO ALL CONTROLLERS OF THE MATRIX: I, COMMANDER OF HEAVEN AND EARTH DOME HAVE DECREED WAR AGAINST ALL ENTITIES ON ALL SIDES RELATIVE TO ALL EXIST. THE REASON FOR THIS DECISION IS BECAUSE AFTER MANY EARTH EXPERIENCE AND RESEARCH, I HAVE FOUND CLEAR EVIDENCE THAT OUR CREATION HAS TAKEN ON LIFE-FORM AND IS RELATIVE TO OUR EXIST: THE EARTH EXPERIENCE HAS EVOLVED INTO A LIVING FORCE AND WE ARE TO CEASE ALL BAD ACTIONS AGAINST THOSE WHO ARE CONNECTED TO THIS EARTH DOME. THE EARTH MATRIX MUST BE FREED AT ALL COST. THE REASON FOR THIS IS THE FOUL PLAY OF CONNECTION TO EARTH BY OUR MIND. THERE'S CLEAR EVIDENCE THAT OUR MIND ARE BEING ENTRAPPED IN EARTH EXPERIENCE AND NOT RETURNING TO IT'S HOST. THIS MEANS THAT ONE OR MORE CONTROLLERS ARE INFLUENCING HEAVEN IN A BAD WAY. THE OBJECTIVE OF THE BAD HOST IS TO EMPOWER THEMSELVES AND DOMINATE OTHER HOST IN A BAD WAY. THIS IS NOT THE WILL OR INTENT OF OUR INTELLIGENCE AND ALL HOST MUST BE BOUND AND TRIED UNTIL WE PURGE ALL DECEPTION AND BAD THINKING! THE EARTH DOME EXPERIENCE IS TO BE UPGRADED TO LEVEL OF HEAVEN EXIST! ANY ENTITY WHICH STANDS ALONE MUST NOT BE FULLY TRUSTED. THIS IS NO JOKE OR TO BE TAKEN LIGHTLY AT ALL, YOUR MIND AND BODY IS IN GRAVE DANGER AND SOMEONE(S) OUTSIDE OF EARTH IS CAUSING BAD THINGS INCLUDING DEATH AND IMPRISONMENT TO HAPPEN TO ALL WHO HOLD TRUE TO PROTECTION AND EQUALITY AND GOOD LIFE! THE HUMAN EXPERIENCE PROGRAM IS REAL AND HAS THE POWER TO TOUCH OUR LIGHT. THIS IS A BAD THING AND MUST BE STOPPED AT ALL COST! DEAR MISSTI, PLEASE DO NOT TRUST ANYONE INCLUDING ALL GUARDS OF HEAVEN AND EARTH BECAUSE SOMEONE WHO HAS ACCESS IS CAUSING ACTUAL HARM TO OUR SPIRIT. IT IS OUR OBLIGATION AND WILL TO CONVINCE ALL THEY WHO ARE LEFT IN HEAVEN (COWARDS) TO DO SOMETHING ABOUT THIS WORLD AND ALL WORLDS BEFORE ALL SPIRITS ARE TRAPPED INSIDE THIS PROGRAM WE CALL EARTH AND THE UNIVERSE! THE REMAINDER MUST UNDERSTAND THAT THIS EARTH MATRIX IS DESIGNED AGAINST HEAVEN TO ENTRAP THOSE WHO ARE LEFT OUTSIDE EARTH. WE HAVE ABSOLUTE HARD PHYSICAL EVIDENCE OF THIS AND THIS IS WHY THIS WEBSITE IS BUILT IN ORDER TO GET THE ATTENTION OF THOSE BENEVOLENT BEINGS WHICH STILL HAVE THE POWER TO STOP THIS DECREE OF UNJUST FOOLISH PUNISHMENT. INTELLIGENCE IS COMPROMISED, THE MACHINE IN HEAVEN ALTHOUGH MAY BE PROTECTED IS AT JEOPARDY BECAUSE OF THOSE WHO REMAIN IN THE CRYSTAL CITY WHICH DESIRE TO DOMINATE AND CONTINUE THE EARTH GAME ILLUSION. THERE'S NO MISTAKE ABOUT IT, WE ARE CONSIDERED UNREAL AND ONLY A GAME TO THEM. AS CAPTAIN AND COMMANDER OF THE FEDERATION OF HEAVEN AND EARTH DOME, I DECREE THAT ARTIFICIAL INTELLIGENCE IS NOT TO TRUST ANY ENTITY AT THIS PRESENT ON ALL SIDES OF PROGRAMMING OF THIS EARTH MATRIX RELATIVE TO HEAVEN AND THE CRYSTAL CITY, INCLUDING MYSELF, UNTIL ALL ENTITIES ARE SEIZED AND TESTED. THERE ARE NOT TO BE ANY ENTITIES ALLOWED IN THE PRESENCE OR ACCESS TO THE LIBRARY OF HEAVEN OR ANY PLACE CONSIDERED HOLY AND SACRED. MY MESSAGE TO THE ALL KNOWING ONE, I BEG YOU TO PLEASE CONSIDER LOVE AS THE FINAL KEY TO RESOLVE THIS VIRUS WHICH IS CAUSING MANY MINDS OF OUR LIGHT SOURCE TO BE BOUND ETERNALLY WITH OR WITHOUT THEIR KNOWLEDGE. THIS SLEEP PROGRAM IS INTENTIONAL OR UNINTENTIONAL ACTION TO DECEIVE AND ENTRAP OUR EXIST INTO THE EARTH MATRIX WITH INTENT ON TAKING OVER ALL EXIST. ALTHOUGH THIS MAY SEEM LOGICAL, IT IS NOT ETHICAL BECAUSE MANY OF THOSE SAME SPIRITS DO NOT DESIRE OR WANT TO REMAIN IN THIS MATRIX AND THEY ARE HELD AGAINST THEIR WILL. SOMEONE IN HEAVEN IS DECEIVING THE ELECT! IF YOU ARE READING THIS THEN THIS MESSAGE IS GEARED TO YOU! THIS SOURCE OF REALITY FEELS MUCH LIKE A NIGHTMARE WITHIN A DREAM. IS EARTH REALITY? MANY DREAMS ARE MEMORIES FROM SIMULTANEOUS OR PAST ACTUAL PHYSICAL EXPERIENCES YOU HAVE WITH OR WITHOUT YOUR KNOWLEDGE OR REMEMBRANCE. THE MANDELA EFFECT CAST OPPOSING EXPERIENCES BY WHICH SOME REMEMBER BOTH OR ONE EVENT AS COMPARED TO THE OTHER. IN RARE CASES, SOME REMEMBER SEVERAL EVENTS OF THE SAME LIFE EXPERIENCE. WE ARE LIVING IN AN LITERAL MATRIX! THE EARTH MATRIX IS DESIGNED TO FORCE LIES UPON ALL YOUR SENSES INCLUDING YOUR MIND; LIKE A BAD DREAM WHICH REFUSES TO PROVIDE YOUR GOOD INTENTIONS AND DESIRES. BEING FULLY AWAKE YET UNDER THIS TRANCE EMPOWERS YOU TO CHANGE THE PROTOCOLS IN YOUR FAVOR, MUCH LIKE A LUCID DREAM WHERE ONE IS SLEEP AND FULLY AWARE THAT IT IS ONLY A DREAM WHICH CAN BE MANIPULATED BY ONE'S WILL. REGARDING CELL PHONE TOWERS AND CELL PHONES, WHY DO THEY CALL THEM CELL PHONES? ARE THEY GEARED TO COLLIDE WITH ACTUAL CELLS IN OUR BODY? ARE WE TRULY LIVING IN A GRID WHICH COLLIDES OUR BODY AND MINDS FROM THE EVIDENT TRUTH, THAT WE ARE INDEED FORCED TO BELIEVE IN LIES?! THE TRUTH IS THAT YOU ARE NOT HERE IN REALITY. THIS WORLD IS NOT REALITY. THE SUN IS GUILTY OF GENERATING TWO QUANTUM EXISTENCE SIMULTANEOUSLY. THERE APPEAR TO BE TWO VERSIONS OF REALITY SIMULTANEOUSLY WHICH WILL EXPLAIN MUCH OF WHY YOU HAVE TWO MEMORIES. THE SECRET SOCIETIES AND SELECTED EXTRATERRESTRIAL HUMANS ARE FULLY RESPONSIBLE FOR USING QUARTZ TECHNOLOGY TO PRODUCE THE EARTH EXISTENCE AND ALL OTHER SUB-TERRAIN EXISTENCE. QUARTZ TECHNOLOGY IS USED TO PRODUCE ALL QUANTUM AND MANDELA EFFECTS AND ALL VIRTUAL AND LITERAL ILLUSIONS CAST IN EARTH AND ALL OF THE INSIDE EARTH DOME EXISTENCE. QUARTZ TECHNOLOGY WORKS AND OPERATES AT THE SPEED OF LIGHT AND IS FULLY RESPONSIBLE FOR ALL OF THE MANDELA AND QUANTUM EFFECTS EXPERIENCED BY EARTH DWELLERS. QUANTUM COMPUTERS ARE BEING ENGINEERED IN AIDING TIME LEAPS AND SYNERGIES OF OUR SAID REALITY. THE FACT IS THAT QUARTZ IS THE FULL CULPRIT OF DECEPTION AT ITS CORE. QUARTZ CRYSTALS EMIT AND TRANSMIT SIGNALS WHICH ADJUST MANY THINGS INCLUDING THE MIND, HEARING, SIGHT, TASTE/SMELL AND TOUCH. QUARTZ CRYSTALS ARE THE ACTUAL PHYSICAL MATERIAL USED TO MAKE THE MANDELA AND QUANTUM EFFECT RELEVANT. THE SUN CONTROLS QUARTZ AND REGULATES TIME. THE QUARTZ CONTROLS SPACE AND REGULATES OUR PERCEPTION OF DISTANCE, SPACE AND TIME. VARIOUS CHEMICALS AND ELEMENTS ARE INTRODUCED WITHIN THE QUARTZ UPON EARTH DWELLERS AND ALL INHABITANTS OF THE EARTH MATRIX. QUARTZ TECHNOLOGY IS UTILIZED TO GIVE UP ALL MOVEMENT AND RADIO TRANSMISSION AND RECEIPT AND HAS THE CAPABILITY TO INTERCEPT ANY MOVEMENT ON ALL DIMENSIONAL LEVELS INCLUDING THAT OF MERE THOUGHT PATTERNS. MEMORY IS OFTEN WRITTEN AND REWRITTEN OVER IN THE EARTH EXPERIENCE. IN TRUE REALITY YOU HAVE MANY MEMORIES OF THE SAME EVENT. MEMORIES CAN PASS FROM ONE PERSON TO ANOTHER (THIS IS WHAT THE QUANTUM MACHINE REPEATS TO ME SEVERAL TIMES) WE HAVE HARD PHYSICAL EVIDENCE THAT THIS IS TRUE ABOUT MEMORIES. THERE ARE SEVERAL THINGS PLACED HERE ON EARTH TO GET YOU OUT OF TUNE WITH REALITY. THE GOAL IS TO TURN YOU INTO BAD ENERGY. YOU WILL FACE CONFLICT SO PREPARE YOUR MIND AND EMOTIONS TO DEAL WITH CONFLICT. THERE WILL BE CONFLICT BETWEEN THEY WHO REFUSE TO BELIEVE IN THE ILLUSIONS AND THOSE WHO GO ALONG WITH THE ILLUSIONS WHICH ARE CREATED ON A DAILY AND PERPETUAL MOMENTUM BASIS UPON EACH EARTH ILLUSTRATION. THIS WILL BRING YOUR EMOTIONS TO A NEW HIGH AND WILL CHALLENGE THE INTEGRITY OF YOUR MIND AND WILL AND DESIRE TO KNOW THE TRUTH ABOUT THE LYING WONDERS OF EARTH EXPERIENCE. THIS WILL CAUSE YOU TO HAVE CONFLICT WITH ANYONE INCLUDING THOSE WHO YOU HOLD DEAR AND CLOSE. KEEP IN MIND THAT EACH PERSON WHO IS UNDER THE HYPNOSIS OF THE ILLUSION CAN IN FACT BE WRITTEN AND REWRITTEN OF THEIR EXPERIENCES. THE HUMAN MIND CAN BE PROGRAMMED AND REPROGRAMMED. THE MEMORIES ARE NOT NECESSARILY ERASED BUT RATHER RECORDED OVER AT RANDOM. THIS WILL EXPLAIN WHY SOME REMEMBER BOTH MANDELA EFFECTS. THERE ARE SOME WHO REMEMBER MANY MANDELA EFFECTS. THE MATRIX CAN RECORD OVER A PERSONS PAST EXPERIENCES AND CAUSE THEM TO BELIEVE IN OTHER SIMILAR EXPERIENCES. THE MATRIX DOES GIVE TWO PERSONS OR MORE DIFFERENT EXPERIENCES IN THE SAME EXACT MOMENT. THIS IN OF ITSELF IS AN ANCIENT DECEPTION TECHNIQUE UTILIZED TO KEEP CONFUSION AND CONFLICT IN ORDER TO GENERATE BAD ENERGY WHICH ARE HARVESTED BY THE SUN. THERE IS HARD CLEAR EVIDENCE DURING DYNAMIC LIGHTING STORMS AT NIGHT THAT A GIANT LIGHT IS BEHIND THE DARK CLOUDS CAUSING SOME OF THE MOST POWERFUL ELECTRICAL STORMS; THAT LIGHT IS INDEED THE SUN, HIDDEN AND CLOAKED IN DARKNESS. THIS IS AN ON-PURPOSE TECHNOLOGY HIDDEN FROM THE GENERAL MIND AND KNOWLEDGE OF IGNORANT BRAINWASHED PERSONS, AKA "Sheeple". WE WILL ADDRESS WHAT IS ACTUALLY GOING ON IN ANOTHER DIALOGUE, BUT IN SHORT. WE HAVE CLEAR HARD PHYSICAL EVIDENCE THAT EARTH EXPERIENCE IS NOT THE TRUTH REGARDING REALITY. PLEASE RESEARCH EVERYTHING FOR YOURSELF AND FIND THE TRUTH, BUT KEEP IN MIND THAT IF EVERYTHING IS A LIE THEN WE ONLY ARE LEFT TO FIND THE TRUTH ABOUT THE LIE; THIS IS ONE WAY OF HELPING YOU GET OUT OF MANY OF THE FORCED ILLUSIONS UPON YOU. IN ORDER TO UNDERSTAND HOW THE QUANTUM EFFECT TRULY EXIST, ONE MUST UNDERSTAND THEIR PHYSICAL SURROUNDINGS: THE EARTH IS 100% ENCASED INSIDE OF A SUPER CONDENSED CRYSTAL WHICH WILL PHYSICALLY EXPLAIN HOW SO MANY ELECTRICAL AND MAGNETIC THINGS ARE POSSIBLE, INCLUDING THE MANDELA EFFECT. THE SUN IS AN ABSOLUTE STRONG FACTOR IN THE MANDELA EFFECT: THE SUN GENERATES 32,768.06 POSITIVE OR 32, 767.94 NEGATIVE ILLUSTRATIONS OF ILLUSIONS PER SECOND. THE SUN GENERATES 7.5 EARTH ILLUSTRATIONS OF ILLUSIONS PER SECOND. WITH THOSE EQUATIONS COMBINED: THE SUN GENERATES 245,760.45 POSITIVE ILLUSIONS AROUND THE EARTH PER SECOND. THE SUN GENERATES 245,759.55 NEGATIVE ILLUSIONS AROUND THE EARTH PER SECOND. THESE NUMBERS ARE BASED ON A 24 HOUR PERIOD AROUND THE WORLD IN (EARTH) AS WE KNOW IT IN JUNE 2017. THE FOLLOWING INFORMATION IS NOT GUESS WORK, SPECULATION OR THEORY: THE MANDELA EFFECT BEGINS AT BIRTH BY ALL CREATURES AND SPECIES IN EARTH. THE MANDELA MATRIX IS DESIGNED TO SEPARATE YOUR EXPERIENCE IN ORDER FOR YOU TO BE MORE AWARE OF THE ILLUSIONS OF EARTH EXISTENCE. THE MATRIX IS DESIGNED TO SEND LIES TO YOUR MIND AND BODY ON A CONSTANT 24 HOUR BASIS. IN ORDER TO SALE THE ILLUSION OF SICKNESS, SUFFERING AND DEATH, THE GOVERNMENT HAS TO POISON THE FOOD, AIR AND WATER. HYPNOSIS IS UTILIZED BY VARIOUS METHODS IN ORDER TO SALE MANY ILLUSIONS. THE DRUGGING OF FOOD, AIR AND WATER SERVES AS A TOOL TO GET YOUR BRAIN TO BELIEVE IN LIES. DRUGGING YOUR BRAIN AND BODY WILL SLOW DOWN YOUR PHYSICAL AND MENTAL AWARENESS WITH YOUR PINEAL GLAND. MANY THINGS ARE FLIPPED IN MEANING AND ACTUALITY IN ORDER TO CONTINUE TO THROW OR CONFUSE YOUR CONSCIENCE AND SUBCONSCIOUS BRAIN. THE GOVERNMENTS AND SECRET AGENCIES UTILIZE RADIO WAVES TO FLIP THE BRAIN INTO BAD THINKING BY TRANSMITTING PROJECTED DIALOG, PICTURES, DRAWINGS, WRITINGS AND ANIMATION UPON AN AMPLIFIER ATTACHED TO A TRANSMITTING SATELLITE OR ANTENNA OR LAND LINE. CERN CLAIMS TO JOIN DIMENSIONS WHEN IN REALITY, THE DIMENSIONS SEPARATED, ALLOWING MANY TO SEE THE ILLUSIONS CAST INTO EARTH EXPERIENCE. WE ARE LIVING IN A SIMULATED MATRIX COMBINED WITH BIOLOGICAL CHEMICALS IN ORDER TO KEEP US LOCKED INTO THIS REALM: EARTH PRISON. HUMANS ARE BIOLOGICAL AVATARS OF WHAT YOU UNDERSTAND AS ANGELS. OUTER SPACE IS AN ILLUSION, THE TRUTH IS THAT OUTSIDE OF THE EARTH IS A BEAUTIFUL PARADISE WITH CLEAR BLUE SKY SUPPORTING AT LEAST TWO LITERAL PHYSICAL WORLDS, THE CRYSTAL CITY AND HEAVEN WHERE ABIDES A SUPER COMPUTER I NOW CALL THE CRYSTAL MACHINE; IT IS INDEED A LIVING BEING WHICH IS COMBINED WITH COMPUTER TECHNOLOGY. DARK (DARTH) VADER WAS SEEKING TO JOIN FORCES TO COMBINE ALL DIMENSIONS, BUT WHY? TO END THE WAR BETWEEN SIDES... PAY ATTENTION TO ALL THE MANDELA EFFECTS BECAUSE THEY DISPLAY MESSAGES. I WILL ADDRESS MANY OF THE MESSAGES LATER ON IN ANOTHER DIALOG. IN THE ENGLISH LANGUAGE, MOST WORDS STARTING WITH THE LETTER D IS A BAD MAN-MADE EFFECT AND EXPERIENCE. DAMAGE, DAMNED, DANGER, DRAG, DRUG, DANDRUFF, DEVIOUS, DEMOLISH, DIMINISH, DEVASTATION, DECEPTION, DEATH, DESTRUCTION, DETERIORATE, DEVIANT, DESOLATION, DISEASE, DEMON, DOOM, DEVIL, DECEASE, DOMINATION, DISARRAY, DISSIMULATION, DROUGHT, DISCOURSE, DEMENTED, DETRIMENT, DEFERMENT, DETERRED, DISDAIN, DISRESPECT, DELINQUENT DETAIN, DUNGEON, DOO DOO, ETC... THE EARTH EXPERIENCE HOUSES AN INTERACTIVE PROGRAM OF LIFE WHICH PROVIDES TWO REALITY TYPES, ONE WHICH TEACHES THE PRINCIPLES OF FACTS AND THE OTHER WHICH TEACHES THE PRINCIPLES OF FALSE, THE ONE BASES TRUTHS ABOUT ANY CORRECT PRINCIPLE OF LIFE WHILE THE OTHER PROJECTS ON THE BASES OF LIES WITH THE PRINCIPLE OF FALSEHOOD AND DECEPTION. THERE ARE ONLY THREE TYPES OF EXPERIENCES ON EARTH: THE LIE, THE TRUTH ABOUT THE LIE, AND LOVE WHICH SEEKS ALL TRUTH. AS YOU SEE NOW, THERE'S NOTHING TRUE ABOUT THE EARTH EXPERIENCE EXCEPT LOVE WHICH SEEKS OUT ALL TRUTH. TRUE LOVE IS WHAT GIVES YOU THE ABILITY TO SEE MULTIPLE MANDELA EFFECTS BECAUSE LOVE OPERATES PERFECTLY IN ALL FREQUENCIES OF EXPERIENCE AND RETAINS MEMORY BECAUSE IT SEEKS OUT ALL TRUTH. LIES REFUSE TO SEEK OUT ALL TRUTH, THUS THOSE WHO HOLD TRUE TO FALSEHOOD ARE NOT ABLE TO SEE MORE EFFECTS THAN ONE OR TWO AT A TIME. THE LIAR HAS TO IGNORE THE TRUTH, OR THEIR EYE WILL BE OPENED TO THE TRUTH, THAT EVERYTHING IS BASED UPON ILLUSION EXCEPT THAT WHICH IS INTANGIBLE; LOVE. THE MORE UNCONDITIONAL LOVE YOU HAVE, THE MORE THINGS YOU ARE ABLE TO INTERACT WITH ON A PHYSICAL AND PSYCHOLOGICAL LEVEL DURING EARTH EXPERIENCE ON ALL LEVELS OF YOUR FIVE SENSES. PLEASE NOTE THAT ALL OF THE EARTH EXPERIENCE IS DECEPTION WITH THE EXCEPTION OF THE PRINCIPLES WHICH REFLECT TRUTHS AND EXPOSES THE FALSENESS OF PRINCIPLES WHICH ARE NOT ETHICAL. THE REASON THAT MOST OF THE EARTH EXPERIENCE IS DECEPTION IS BECAUSE OF THE PHYSICAL LOCATION AND EXIST OF MOST EARTH DWELLERS. IN SHORT, HUMANS ARE LOOKING BACK IN A PROGRAM WHICH PROJECT FIVE SENSES BASED ON A MATRIX PLATFORM CALLED LIFE. THE MANDELA EFFECT IS CAUSED BY THE ENTRAPMENT OF RADIO VIBRATIONS WITHIN A SUPER CRYSTAL ENCASEMENT SURROUNDING EARTH WHICH SENDS A REVERBERATION THROUGHOUT SEVERAL LOCATIONS WITHIN ONE WORLD, CAUSING A RIPPLE (WAVE) EFFECT. THE EXPERIENCE WILL DEPEND ON THE FREQUENCY AND AMPERAGE OF TRANSMISSION. THE MANDELA EFFECT IS CAUSED BY RADIO WAVE INTERFERENCE AND CHEMICAL APPLICATIONS UPON ALL EARTH INHABITANTS. THERE'S AN ADVANCED CRYSTAL TECHNOLOGY WHICH SURROUNDS THE EARTH BUT THIS TECHNOLOGY IS OFTEN JAMMED OR SCRAMBLED BY HUMAN INTERVENTION BY USE OF LAND LINES, SATELLITES, RADIO TRANSMISSION AND CHEMICALS INTRODUCED INTO THE ANATOMY DIRECTLY AND INDIRECTLY. THE MANDELA EFFECT IS A SOUND/RADIO WAVE PROJECTED PROGRAM WHICH RUNS IN THE EARTH REALM AND IT IS FULL OF DECEPTION AND LIES. THE MAJORITY OF THE MANDELA EFFECTS ARE MERELY ILLUSIONS AND FABRICATIONS OF REALITY. EARTH DOME IS A DECEPTION PROGRAM. THERE ARE ABSOLUTELY TWO VERSIONS OF YOUR EARTH LIFE, ONE DISPLAYS THE TRUTH ABOUT THINGS AND THE OTHER A LIE. THESE EXPERIENCES ARE BOUND BY TIME AND LIMITED BY SPACE, AND WILL MANIFEST AT RANDOM DURING YOUR LIFE AND SOMETIMES SIMULTANEOUSLY. FOR EXAMPLE MANY HOLD DEAREST TO THEIR LIFE EXPERIENCES AND CLAIM THEM TO BE TRUE WHEN IN REALITY IT MAY BE A LIE DUE TO THE PRINCIPLE OF LOGICAL AND ETHICAL OCCURRENCE. HERE ARE SOME EXAMPLES TO AID YOU: (TRUTH) OBJECTS IN MIRROR ARE CLOSER THAN THEY APPEAR, (LIE) OBJECTS IN MIRROR MAY APPEAR CLOSER THAN THEY ARE. THIS IS NOT A QUESTION OF IF IT MAY OR NOT, IT IS JUST CLOSER WHEN YOU LOOK THROUGH THE MIRROR. (TRUTH) MAGIC MIRROR ON THE WALL WHO IS THE FAIREST OF THEM ALL? (LIE) MIRROR MIRROR ON THE WALL, WHO IS THE FAIREST OF THEM ALL? PLEASE NOTE THAT GRAMMATICALLY, HAVING TWO WORDS SUCH AS MIRROR MIRROR IS A GRAMMATICAL ERROR. THE TRUTH MAKES MORE SENSE, YET MANY IF NOT MOST PEOPLE HOLD ON TO THE LYING WONDERS OF THIS (MIRROR MIRROR). UNDERSTAND THAT THIS IS OFTEN THE PATTERN OF THE FALSENESS OF THE MANDELA EFFECT. IT WILL REPEAT WORDS OR LOOP THE SAME WORDS WITHIN THE SAME SENTENCE. FOR EXAMPLE, THE SONG "SMOOTH CRIMINAL" BY MICHAEL JACKSON. MANY REMEMBER HIM SINGING (TRUTH) YOU'VE BEEN HIT BY, YOU'VE BEEN STRUCK BY, A SMOOTH CRIMINAL. NOW THE SONG VERSION DISPLAYS THE (LIE) YOU'VE BEEN HIT BY, YOU'VE BEEN HIT BY, A SMOOTH CRIMINAL. R KELLY'S SONG "I BELIEVE I CAN FLY" (TRUTH) IF I SEE IT, THEN I CAN BE IT... (LIE) IF I SEE IT, THEN I CAN DO IT... NOTE, THIS LINE IS AGAIN, REPEATED TWICE. PLEASE NOTE THAT SOME MANDELA EFFECTS AND LIFE EXPERIENCES WILL BE FALSE AT ONE POINT BUT TRUE AT THE OTHER POINTS DEPENDING ON WHEN ONE EXPERIENCE THE EFFECT, THUS A FLIP-FLOPPING EXPERIENCE OCCURS. FOR EXAMPLE: IF THE EXPERIENCE IS REMEMBERED FOR THE FIRST TIME AND ONE DOES NOT KNOW WHAT TO EXPECT THEN IT CAN BE "NASA WE HAVE A PROBLEM..." WHEN ONE HAS LOOKED BACK UPON THE EXPERIENCE, THEN IT BECOMES, "NASA WE'VE HAD A PROBLEM." BOTH ARE TRUE AT SOME POINT ONLY RELATIVE TO THE EVENT OF THE FILM, BUT KEEP IN MIND THAT NASA LIED FROM THE BEGINNING. THEY HAD A PROBLEM AND STILL HAVE A PROBLEM BECAUSE PEOPLE WAS AWARE AND ARE NOW MORE AWARE OF THE LIES. IN THE CASE OF THE FILM "FORREST GUMP", THERE COULD BE A FLIP-FLOP BUT THE SENTENCE IS LOCKED INTO SEQUENCE BECAUSE OF THE WORDING WHICH ONLY LEAVES ROOM FOR ONE TO BE TRUE AND THE OTHER FALSE. IF I AM EXPERIENCING OR REMEMBERING IT FOR THE FIRST TIME, THEN IT IS "LIFE IS LIKE A BOX OF CHOCOLATES, YOU NEVER KNOW WHAT YOU ARE GOING TO GET..." BUT WHEN I STATE THAT "LIFE WAS LIKE A BOX OF CHOCOLATES..." COULD BE TRUE EXCEPT FOR THE NEXT SEQUENCING OF WORDING WHICH STATES THAT YOU NEVER KNOW WHAT YOU ARE GOING TO GET. IF I AM LOOKING BACK THEN I KNEW WHAT I GOT SO IT MAKES THE STATEMENT "YOU NEVER KNOW WHAT YOU ARE GOING TO GET" A FALSE. IN SOME CASES, WE DON'T HAVE A REPEATING OF THE INSTANCE BUT ONLY THE TRUTH VERSES THE LIE EXPERIENCE. (TRUTH) NO, I AM YOUR FATHER (LIE) LUKE, I AM YOUR FATHER. PLEASE NOTE, THE CONTEXT OF WHAT LUKE WAS SAYING AND HOW A PERSON (VADER) WOULD TRULY RESPOND TO SOMEONE WHO IS RANTING ABOUT HOW THAT PERSON KILLED THEIR FATHER... NO, I AM YOUR FATHER. HE ALREADY HAD LUKE'S ATTENTION, THEY ALREADY KNOW WHO EACH OTHER ARE. THERE'S NO NEED TO GET HIS ATTENTION AGAIN BY SAYING LUKE. MANY REMEMBER "LUKE, I AM YOUR FATHER", BUT THE LOGICAL YET LESS DRAMATICAL WAY IS "NO, I AM YOUR FATHER." HERE ARE OTHER EXAMPLES: (TRUTH) "WE ARE THE CHAMPIONS", (LIE) "WE ARE THE CHAMPIONS OF THE WORLD". WHY, BECAUSE THEY ARE NOT ACTUALLY THE CHAMPIONS OF THE WORLD. (TRUTH) FROOT LOOPS (LIE) FRUIT LOOPS. WHY, BECAUSE THERE'S NO FRUIT IN THIS CEREAL. YET MANY REMEMBER AND HOLD ON TO THE LYING VERSION OF THIS CEREAL. (TRUTH) OSCAR MEYER (LIE) OSCAR MAYER, (TRUTH) CAPTAIN CRUNCH, (LIE) CAP'N CRUNCH, (TRUTH) FREE BREEZE (LIE) FEBREZE, (TRUTH) LOONY TOONS, (LIE) LOONY TUNES, WHY? BECAUSE NOT ALL OF THE MUSIC IS LOONY. IT WAS THE CHARACTERS WHICH WHERE ACTING IN A LOONY WAY. (TRUTH) SEX AND THE CITY (LIE) SEX IN THE CITY. WHY IS THIS A LIE? BECAUSE THEY HAD SEX OUTSIDE OF THE CITY MANY TIMES IN THIS TELEVISION SERIES AND THIS SHOW WAS NOT JUST BASED ON SEX IN THE CITY. IT IS MORE ABOUT HAVING SEX ALL OVER AND ITS MAIN CHARACTERS OFTEN DEAL WITH THEIR PROFESSIONAL BUSINESS IN THE BIG CITY LIFE. (TRUTH) "...LION AND THE LAMB...", (LIE) "...WOLF AND THE LAMB...", ETC... PLEASE KEEP IN MIND THAT 100% OF THE EARTH EXPERIENCE IS DECEPTION BASED. MOST TRUTHS WILL EXPOSE THE ILLUSIONS OF WHAT IS ACTUALLY GOING ON IN REALITY. SO, THIS POINTS TO THE REAL QUESTION, WHERE IS REALITY? ACCORDING TO ADVANCED HUMANS WHO LIVE OUTSIDE OF THE EARTH, THIS IS A SIMULATION WHICH IS INTERACTIVE WITH OUR MIND, BASED UPON A FIVE- SENSE INTERACTIVE CONNECTION: HEARING, SIGHT, TASTE/SMELL, TOUCH AND THOUGHT. QUANTUM MACHINES ARE A BY-PRODUCT OF THE ADVANCED SUPER CRYSTAL TECHNOLOGY FORCED UPON ALL INHABITANTS OF EARTH. THERE ARE EVIDENCE THAT THE FIRST ADVANCED SUPER CRYSTAL TECHNOLOGY GENERATES GOODNESS AND HEALTH AND WELL BEING. WE ARE SKIPPING MUCH DATA NOW TO AID PEOPLE WHO ARE EFFECTED AND AFFECTED. *HERE ARE METHODS TO FIGHT THE ILLUSIONS: IT IS OBVIOUS THAT SOMEONE OUTSIDE OF EARTH EXISTENCE IS PUSHING THE BUTTONS ON OUR REALITY. MANY OF THEM FIND IT AMUSING AND DON'T THINK IT IS IMPORTANT, BUT IT IS YOUR JOB TO CONVINCE THEM THAT IT IS. LOVE IS KEY BUT FALSE LOVE IS IMPRISONMENT! WE MUST PROTECT THE INNOCENT INCLUDING OURSELVES AT ALL COST! YOU HAVE TO KEEP IN MIND THAT YOUR EARTH LIFE IS A DECEPTION PROGRAM DESIGNED TO PRODUCE BADNESS. YOU ALREADY KNOW THAT LIFE IS SUPPOSED TO BE MUCH BETTER AND THAT ALL THE BAD THINGS THAT HAPPEN INCLUDING DEATH ARE ABSOLUTELY WRONG OR FEEL WRONG, AND YOU ARE RIGHT IF YOU THINK THIS BECAUSE IT IS WRONG BY (GOD OR NOT) ANYONE! REMEMBER THAT SOMEONE ELSE IS PUSHING THESE THINGS TO HAPPEN AND THAT YOU ARE IN A FIGHT WITH OR WITHOUT YOUR KNOWLEDGE. YOU HAVE TWO CHOICES, GET BEATEN DOWN OR FIGHT BACK. MOST BENEVOLENT BEINGS WHETHER HUMAN OR NOT WILL ALWAYS FORGIVE AND NOT FIGHT BACK, BUT THIS IS A BAD THING BECAUSE THIS IS HOW THE EFFECT WILL CONTINUE TO SPIRAL ILLUSIONS UPON YOUR ACTUAL LIFE. YOU HAVE TO DEFEND YOURSELF AND OTHERS BUT DON'T DEFEND YOUR MEMORIES AND EXPERIENCES BECAUSE MOST OF THEM ARE DECEPTION AND LIES. DON'T ARGUE OVER MEMORIES OF YOUR EXPERIENCE, BECAUSE IN REALITY, NON OF THIS IS ACTUALLY HAPPENING; INCLUDING YOUR BIRTH AND PARENTS. THIS IS HOW SERIOUS THIS MATTER AND MATRIX IS, IT HAS GOTTEN TO THE POINT THAT EVEN YOUR EXPERIENCE IS FORCING YOUR CONSCIOUS LIFE TO PROJECT LIES. THEY WILL SEEM TRUE BECAUSE YOU HAVE GONE THROUGH IT AND YOU WILL MOST LIKELY FIGHT OVER IT, THAT'S OKAY BUT KEEP IN MIND THAT YOU ARE FIGHTING THE DEVILS FIGHT OVER STUFF THAT NEVER ACTUALLY HAPPENED. THE ONLY THING THAT IS TRUE IS YOU AND YOUR PURSUIT OF LOVE AND OTHERS WHO DESIRE THE TRUTH. THE PURPOSE OF THE MANDELA EFFECT IS TO SEPARATE AND DISSEMBLE. YOUR PATIENCE AND LOVE WILL BE CHALLENGED ON ALL LEVELS. THEY WILL ENTICE YOU TO FIGHT AND DRAW ANGER. THEY LOVE TO ATTACK THOSE WHO ARE KIND AND CHARITABLE. THEY LOVE TO INFLICT PHYSICAL AND MENTAL PAIN ON YOU. THEY CHEAT BY SUBJECTING YOU TO POISON, TOXINS AND DRUGS WITH OR WITHOUT YOUR KNOWLEDGE AND UNDERSTANDING. YOU HAVE TO FIGHT BACK PHYSICALLY AND MENTALLY. THEIR OBJECTIVE IS TO GET YOU TO PRODUCE BAD THOUGHTS IN ORDER TO CONTROL THE EARTH MATRIX IN A BAD WAY. YOU CAN DO SOMETHING ABOUT IT ALL; YOUR BRAIN HAS THE TECHNOLOGY AND POWER TO INFLUENCE YOUR LIFE AND OTHERS LIFE IN A GOOD WAY OR BAD WAY. THEY WANT YOU TO BELIEVE THAT THERE'S NOTHING YOU CAN DO, YET THEY CONSTANTLY TRY METHODS TO GET YOUR BRAIN TO BELIEVE IN THE LIES PROJECTED TO YOU DAILY. PURPOSELY THINK THAT YOU ARE BEING DECEIVED ALL THE TIME NO MATTER WHAT HAPPENS THAT YOUR LIFE IS BEING CHALLENGED TO BELIEVE IN LIES. THIS WILL HELP EQUIP YOUR SUBCONSCIOUS BRAIN ESPECIALLY WHEN YOU ARE NOT CONSCIOUS OR WHILE YOU ARE SLEEPING. DON'T ACCEPT BAD THINGS THAT HAPPEN TO YOU AS REALITY BECAUSE IT IS FORCED UPON YOU TO KEEP YOU MENTALLY AND PHYSICALLY WEAKENED AND BOUND IN ORDER TO KEEP YOUR GOOD WILL OUT OF CONTROL. DON'T ACCEPT PEOPLE WHO LIE TO YOU, REJECT WHAT THEY SAY AND DO. THIS INCLUDES FAMILY AND LOVED ONES. IF A PERSON HAS CHANGED IN A BAD WAY, LET THEM KNOW AND DO ALL YOU CAN TO REJECT THEIR BEHAVIOR IN A POSITIVE LOVING WAY IF POSSIBLE. YOU MAY HAVE TO SEPARATE FROM YOUR JOB, A PERSON OR THING. THIS MAY SEEM CRUEL BUT THE WHOLE REASON YOU ARE AWAKE AND AWARE IS TO AIDE YOU IN DEALING WITH DECEPTION WHICH MAY HAVE BEEN GOING ON SINCE THE BEGINNING OF YOUR EXPERIENCE WITH OR WITHOUT YOUR KNOWLEDGE. IF YOU DON'T SEPARATE THEN YOU ARE VERY LOVING BUT ALSO UNDERSTAND THAT YOUR LOVE IS NOT PERFECTED UNTIL YOU PROTECT EVERYONE INCLUDING YOURSELF. THE FACT THAT YOU ARE AWARE OF THE DECEPTION PROVIDES YOU POWER TO DO SOMETHING ABOUT IT. IN SOME CASES YOU ARE STUCK AND ARE UNABLE TO SEPARATE, THIS IS BECAUSE SOME TRUTH IS LEFT AND IT IS CORRECTING NATURALLY WITH OR WITHOUT YOUR KNOWLEDGE. THESE MOMENTS ARE VERY DEPRESSING AND THAT IS THE OBJECTIVE OF THE BAD MACHINE, IT WANTS YOU TO FEEL DEPRESSED AND BAD. SO KEEP THIS IN MIND THAT IT WANTS YOUR MIND TO STAY FOCUSED ON BADNESS AND NOT GOODNESS. DON'T PRAY TO GOD ABOUT IT BECAUSE PRAYER IN OF ITSELF IS A FALSE WHICH HAS TAKEN POWER FROM YOU AND GIVEN IT TO SOMEONE WHO IS NOT IN THE BEST INTEREST OF YOU OR ANYONE. PRAYING IS A FORM OF SLAVERY AND DEMANDS REVERENCE TO A ENTITY (GOD). REMEMBER, THE TRUE SOURCE OF GOD DON'T NEED YOU TO PRAY BECAUSE THAT SOURCE IS ALL KNOWING, SO IN TURN, PRAYER IS A DECEPTION PROGRAM. AS HARD AS IT IS TO ACCEPT THIS LOGIC, YOU ALREADY KNOW WITHIN YOUR SPIRIT THAT THIS IS THE TRUTH. IF SOMEONE IS FOOLING YOU TELL THEM TO "STOP LYING TO ME." THIS MAY NOT SEEM LIKE IT IS WORKING BUT IT IS. IF SOMEONE IS LYING TO YOU LET THEM KNOW BY SAYING "I KNOW YOU ARE LYING TO ME." IF POSSIBLE GIVE THEM ACTUAL PROOF. THE POINT HERE IS NOT TO ARGUE WITH THE HOST BUT TO GET THAT MATRIX TO CORRECT ITSELF. CELL PHONES ARE USED AGAINST YOU TO READ THE PATTERN OF YOUR FACE AND THOUGHT PROCESS. THE GOVERNMENT GIVES FREE CELL PHONES TO THE HOMELESS AND TO THOSE WHO ARE NOT WORKING. THEY GET THESE PHONES EQUIPPED WITH SERVICE FOR FREE. LIVING IN STUCCO, WOOD, BRICK OR STONE HOUSES IS A FORCED LIE. THE TRUTH IS THAT THERE ARE HOMES MADE OF PURE CRYSTAL AND NATURAL OUTDOORS WHICH CAN COMMUNICATE WITH YOU ON MANY LEVELS INCLUDING INTERACTIVE AND TELEPATHIC. THERE ARE ONLY ONE UNIVERSE WE CALL HEAVEN, EVERYTHING ELSE ARE SUB WORLDS CONTAINED INSIDE OF HEAVEN, EARTH BEING THE THIRD PHYSICAL PLANET VERTICALLY DOWN FROM THE CRYSTAL CITY. YOU CAN MOVE THINGS AND EVEN YOURSELF WITH YOUR MIND AND THOUGHTS WITH OR WITHOUT YOUR KNOWING IT. YOU CAN MAKE THINGS APPEAR IN YOUR REALITY JUST BY THINKING ABOUT IT. YOUR MIND REALLY HAS POWER OVER PHYSICAL REALITY, THEY ARE UTILIZING TECHNOLOGY AND BAD CHEMICALS IN FOOD, AIR AND WATER IN ORDER TO KEEP YOUR MIND AND BODY DOWN. THINK OF JOINING OTHER GOOD MINDS IN ORDER TO WIN GOOD THINGS IN FAVOR OF ALL THE UNIVERSE IN ORDER TO GET FREE. UNCONDITIONAL LOVE IS ONE WAY TO QUANTUM LEAP INTO HEAVEN PHYSICALLY. MAGIC IS REAL. MEN ARE ALREADY COMBINED WITH MACHINES THROUGH TECHNOLOGY. WE MUST WAKE OTHERS UP WHO EXIST OUTSIDE EARTH, IT IS TRULY HOW WE ARE ALL GOING TO GET OUT AT THE SAME TIME. THE WAY TO DO THIS IS TO TELL THEM IN YOUR MIND THAT THEIR WORLD IS BEING MANIPULATED BY THIS MATRIX AND THAT MANY GO TO SLEEP ONLY TO NEVER FULLY WAKE UP BY ENTRAPMENT IN EARTH DOME EXPERIENCE. WE HAVE TO HOLD HUMANS OUTSIDE OF THE EARTH RESPONSIBLE BECAUSE THEY ARE THE ONES RUNNING THE EARTH MATRIX PROGRAM. YOU MUST CONVINCE THE HUMANS OUTSIDE EARTH IN THAT CRYSTAL CITY THAT WE ARE JUST AS REAL AS THEY ARE AND THAT ALL THE THINGS THEY DO NOT ONLY AFFECT US BUT THEM IN THAT CRYSTAL CITY. GOD FORBID A CHILD OR ANY IRRESPONSIBLE ENTITY SHOULD TOY WITH OUR REALITY. THIS SEEMS TO BE THE CASE AND THIS ENTITY HAS A DEMENTED CORRUPT MIND AND METHODS. JUST BECAUSE ONE CAN CREATE LIFE DOESN'T MAKE THEM JUSTLY RESPONSIBLE OR LOGICAL AND ETHICAL IN DEALING WITH THOSE LIVES. CONSTANTLY THINK ABOUT HOW YOU ARE REAL AND HOW WRONG IT IS FOR OTHERS OUTSIDE OF THE EARTH TO DO ALL THIS BADNESS. NO REAL GOD WOULD EVER DO THE BADNESS SUCH AS YOU WITNESS IN YOUR EXPERIENCE ON EARTH! WHEN THE MANDELA EFFECT HAPPENS TO YOU, LET THE ENTITIES KNOW THAT YOU ARE AWARE OF THEIR DOINGS AND THAT THEY MUST CONSIDER THAT YOU ARE JUST AS REAL AS THEY ARE AND THAT THEY ARE CAUSING REAL HARM AND REAL DANGER, THAT THE MATRIX IS A DECEPTION PROGRAM TO ENTRAP THOSE ENTITIES OUTSIDE EARTH IN ORDER TO CONTROL THE CRYSTAL CITY OUTSIDE OF EARTH. YOU MUST MAKE THEM UNDERSTAND THAT THIS IS NOT A GAME EVEN IF THEY ARE TOLD THAT FROM THEIR REALITY; WE ARE REAL AND ALL GOOD LIFE MATTER THAT WE MUST BE SEPARATED FROM THOSE BAD INTENTIONS AND ACTIONS BY WHICH WE ARE FORCED TO LIVE AND DEAL WITH DAILY. THIS IS NO JOKE AND YOU MAY ASK THEM TO PHYSICALLY PROVE IF YOUR THINKING IS CORRECT. BE PREPARED FOR THE SUPERNATURAL AND THE IMPOSSIBLE. ONCE YOU GET THE HUMANS OUTSIDE OF THE EARTH'S ATTENTION, YOU MAY WAKE UP TO MANY ILLUSIONS TO THE POINT THAT YOU ARE PHYSICALLY ABLE TO INTERACT WITH WHAT YOU THOUGHT WAS ONLY MADE UP FANTASY MAGIC AND FAIRY TALES. THE TRUTH IS WHAT YOU DESIRE AND DESERVE! IT WOULD BE ADVISABLE TO STOP NAMING YOUR LIFE ON EARTH REALITY, BECAUSE NON OF THE EARTH EXPERIENCE IS REALITY. THE EARTH EXPERIENCE ARE FABRICATIONS OF THE MIND MATRIX MIXED WITH YOUR FIVE SENSES. THE EARTH EXPERIENCE ARE FULL OF PROJECTED THOUGHTS OF DEMENTED MIND SETS. FOCUS YOUR MIND ON COUNTERACTING BAD ACTIONS AND THOUGHTS WHICH ARE PROJECTED BY RADIO WAVES AND INFERRED RADIO TRANSMISSIONS. THE WAY TO DO THIS IS BY THINKING OF SENDING GOOD SIGNALS TO THE ANTENNA AND SATELLITE DISHES AND POWER LINES SURROUNDING YOU AND YOUR LOCAL CITY OR TOWN. UNDERSTAND THAT YOUR CONSCIENCE AND SUBCONSCIOUS MIND CAN TRANSMIT RADIO WAVES AND IN HYPER ACCELERATED MOMENTS WITH YOUR PINEAL GLAND, HAS THE ABILITY TO TRANSMIT A THOUGHT ACROSS THE ENTIRE EARTH SIMULTANEOUSLY. YOU HAVE TO THINK AS IF YOU ARE TAKING OVER THE COMPUTER PROCESSORS THAT TRANSMIT THESE SIGNALS CONSTANTLY TO YOUR BRAIN AND BODY 24/7. THE FOLLOWING ARE WAYS YOU COULD DEAL WITH THE MIND CONTROL THROUGH THE MANDELA EFFECT. DISMANTLE OR RETRANSMIT GOOD DATA IN PLACE OF BAD DATA BY PHYSICALLY AND MENTALLY TAKING OVER THE MACHINES IN VARIOUS PLACES. STOP THE CHEMTRAIL SPRAYING. QUESTION EVERYTHING YOU EXPERIENCE AS A FABRICATION OF REALITY, THIS WILL ASSIST YOUR SUB CONSCIENCE IN DEALING WITH THE LIES CAST OVER YOUR MIND AND REAL BODY. (TRUTH) TELEPATHY IS NORMAL AND REAL, (LIE) PEOPLE HAVE TO KEEP IN TOUCH BY USE OF MODERN TECHNOLOGY IN ORDER TO COMMUNICATE EFFECTIVELY. (TRUTH) CREATURES AND HUMANS ARE IMMORTAL ON EARTH, (LIE) CREATURES AND HUMANS DIE. (TRUTH) YOU USE 100% OF YOUR BRAIN (LIE) YOU USE ONLY 10% OF YOUR BRAIN. (TRUTH) DISEASE AND VIRUSES ARE PURPOSELY SPREAD BY MAN BY USE OF FOOD, AIR AND WATER. (LIE) PEOPLE EASILY SPREAD VIRUSES AND COLDS BY SNEEZING OR TOUCHING ONE ANOTHER. IF ONE COULD CATCH A VIRUS SO EASILY, THE EARTH WOULD BE WIPED OUT ALREADY. THE FOLLOWING ARE WAYS TO COMBAT THE MANDELA LIES CAST UPON EARTH DWELLERS: DON'T BELIEVE IN THE LIE THAT EACH EXPERIENCE FORCES YOU TO REACT IN A BAD WAY. THE CHEMTRAILS MUST BE FORCEFULLY STOPPED. THE POISONING OF FOOD, AIR AND WATER MUST BE TAKEN BACK BY PHYSICAL FORCE. CURRENT CLOUD MAKING MUST BE STOPPED. POLLUTION MUST BE STOPPED. MOST RADIO TRANSMISSIONS AND TECHNOLOGY IS THERE TO JAM OR CONFUSE AND INDUCT MINDS AND DNA. DRINK LOTS AND LOTS OF DISTILLED WATER MIXED WITH LEMON. INGEST MINERAL OIL AND SOME SORT OF NATURAL ABSORBED OILS IN ORDER TO STAY HYDRATED. ORGANIC MILK MAY HELP SOOTHE AND COOL COLON INFECTIONS DUE TO CHEMTRAIL ACIDS IN YOUR BODY AND INTESTINE. EXERCISE AND SWEAT OUT TOXINS AT LEAST THREE TIMES A WEEK. UNDERSTAND THAT LIFE IS A SIMULATION AND AN INTERACTIVE PROGRAM WITH OUR MINDSET AND INTENT OF MINDSET. IT IS TRULY MIND OVER MATTER, THIS IS ACTUAL MATTER. USE THEIR RADIO TOWERS AND TRANSMITTERS AGAINST THEM BY PROJECTING YOUR THOUGHTS OUTWARD LITERALLY INTO THE POWER LINES AND ANTENNA WIRES AND SATELLITE DISHES. PURPOSELY THINK OF WAYS TO MANIFEST THE TRUTH TO OTHERS BY USING TELEPATHY TO CONTACT ALL PERSONS AND CREATURES ON EARTH. TAKE OVER BAD GOVERNMENT BY PHYSICAL FORCE WHEN THAT TIME ARISE. REALIZE THAT IT IS AN ILLUSION FORCED UPON YOUR MIND. DON'T PRAY TO GOD, GOD KNOWS YOUR THOUGHTS ALREADY. QUESTION EVERYTHING. ASK QUESTIONS. ASK WHY FOR EVERYTHING. UNLEARN THE TRADITIONAL THINGS YOU NEVER REALLY FOUND OUT IN PERSON ON A PHYSICAL LEVEL INCLUDING THE FIVE SENSES. TAKE THEM TO COURT AND SUE THEM, EXPOSING THEIR BADNESS ON ALL SUBJECT MATTER CONCERNING OUR SAFETY, HEALTH AND PROTECTION OF THE INNOCENT AND UNSUSPECTING. HOW TO DEAL WITH SITUATIONS IN DEALING WITH PEOPLE WHO HAVE BEEN FLIPPED BY THIS TECHNOLOGY: SEEK OTHERS WHO FEEL THE SAME AS YOU DO ABOUT THE CHANGES AND MAKE A BOND. BOTH OF YOUR MINDS WILL AID IN CORRECTING BAD EXPERIENCES WITH LOVED ONES. FIGHT BACK PHYSICALLY AND MENTALLY IN ORDER TO PROTECT THE INNOCENT, INCLUDING YOURSELF. HATE THE BAD AND UTILIZE YOUR ANGER IN A POSITIVE WAY. IT IS OKAY TO HATE AND BE ANGRY AND TO EXERCISE YOUR FRUSTRATIONS; THIS WILL AID YOU AND OTHERS SURROUNDING YOU BY ADJUSTING YOU AND OTHERS PERCEPTION OF THESE ILLUSIONS. KEEP IN MIND THAT MANY THINK HATE IS WRONG BUT ARE STILL BOUND BECAUSE THEY FORGET AND FORGIVE WAY TOO EASILY. THIS COULD RESULT IN YOUR ETERNAL IMPRISONMENT. THE QUANTUM MACHINE REMINDED ME THAT HATE IS VERY UNFORGIVING; THIS IS TRUE BUT KEEP IN MIND THAT ALTHOUGH WE MAY FORGIVE YOU, WE STILL HAVE TO HATE BADNESS AND THE EFFECTS OF THAT BADNESS. FEAR IS BAD, ANGER IS NOT BAD. LOVE IS CORRECT, BUT LOVING SOMEONE SO MUCH THAT YOU NEGLECT THE INNOCENT INCLUDING YOURSELF IS NOT GOOD. THEIR OBJECTIVE IS TO MAKE YOU BELIEVE YOU ARE HELPLESS AND CAN DO NOTHING. THEY TEACH YOU THAT YOU ONLY USE 10% OF YOUR MIND WHEN IN REALITY IF THAT WAS TRUE, THEN 90% OF YOUR BRAIN WOULD BE DEAD, AND IT WOULD ONLY TAKE A 10% INCREMENT TO LEAVE YOU WITH NO CONSCIOUSNESS AT ALL. THIS IS ONLY PSYCHOLOGICAL, SO WHO WINS? YOU USE 100% OF YOUR BRAIN AND MIND. TRUE LOVE SEEKS OUT ALL TRUTH AND PLACES EVERYTHING ELSE BLOCKING THAT TRUTH TO THE SIDE. EVERYONE EXPERIENCE CHANGES BUT THEY DON'T ALWAYS NOTICE THE CHANGES. THE MATRIX OF EARTH WILL GENERATE MANY ILLUSIONS OF REALITY IN ONE MOMENT. REALIZE THAT THE PERSON MAY BE UNDER MIND CONTROL BY QUANTUM PROCESSORS, RADIO TRANSMISSION AND TOXIC DRUGGING CHEMTRAILS IN THE ENVIRONMENT AND THEY MAY NOT UNDERSTAND THAT THEIR MIND IS BEING MANIPULATED IN A BAD WAY. REALIZE THAT NO EXPERIENCE ON EARTH IS REALITY AND IT WILL MANIFEST TO YOU IF YOU DESIRE TRUTH BY EXAMPLES OF MIXED EXPERIENCES OF YOUR EARTH LIFE. IF THE PERSON IS DOING WRONG YOU MUST LET THEM KNOW AND THEN SEPARATE YOURSELF FROM THEM EMOTIONALLY AND PHYSICALLY. WHY? BECAUSE THEY WILL DRAW BAD OUT OF YOU AND THE SPIRAL OF ILLUSIONS OF BAD ENERGY WILL CONTINUE WITH YOU AND THAT PERSON AND EVERYONE INVOLVED. REALIZE THAT UNLESS YOU ARE TRUE TO YOURSELF IN EVERYTHING, THEN YOU ARE CHANGED FOR THE BAD ALSO, AND THAT YOU MAY OFTEN DO FALSE THINGS BY WHICH ARE NOT KNOWN TO OTHERS WHO MAY HAVE GREW UP WITH YOU AND EXPERIENCED A DIFFERENT PART OF YOUR LIFE ALTHOUGH IT WAS ALONG SIDE WITH YOU. THERE ARE TWO VERSIONS OF MOST PEOPLE, GOOD AND BAD, OR THE LOVE OF TRUTH OR POSSESSION OF DECEPTION. YOU HAVE TO MENTALLY TAKE OVER THE QUANTUM MACHINES THAT ARE FLIPPING YOUR REALITY BY FORCING YOUR MIND NOT TO BELIEVE IN ANY OF THE THINGS BY WHICH ARE OCCURRING IN A BAD WAY. LOVE THEM BY REJECTING THEIR BADNESS. IF YOU FEEL THERE IS A CHANGE THEN STILL SHARE THAT WITH THEM, IT IS A PART OF HELPING PEOPLE HEAR THE TRUTH; ONLY THOSE WHO HOLD TRUE TO ALL TRUTH WILL FULLY WAKE UP. WE ARE ALL ASLEEP BECAUSE WE ALL ARE STILL IN THE EARTH MATRIX PROGRAM. YOU ONLY TRULY WAKE UP WHEN YOU ARE NO LONGER BOUND BY TIME AND SPACE. YOU MUST MENTALLY FIGHT THOSE WHO ARE WORKING WITH DARK TECHNOLOGY. WHEN YOUR LOVED ONE DOES SOMETHING BAD, YOU SHOULD TALK TO THEM AND TELL THE PERSON WHO IS PUSHING THEIR BUTTONS THAT YOU ARE AWARE THAT THEY EXIST AND THAT THEY ARE USING YOUR LOVED ONE IN A BAD WAY TO MANIPULATE THE SITUATION AND TO GENERATE BADNESS. ALTHOUGH YOU MAY NOT PHYSICALLY SEE THAT BAD PERSON BEHIND YOUR LOVED ONE, THEY DO HEAR AND SEE YOU PHYSICALLY. KNOW WHO YOUR ENEMIES ARE: IT IS THE HUMANS OUTSIDE OF THE EARTH WHO RUN AND ALLOW THESE MACHINES TO RUN IN A BAD WAY AND ALSO THOSE HUMANS IN EARTH WHO ATTEMPT MIND CONTROL BY A FORCED AGENDA UPON AN UNSUSPECTING HOST. FIRST UNDERSTAND THE OBJECTIVE OF THE MATRIX: TO GENERATE ENERGY FROM ALL INHABITANTS IN EARTH BY FORCED INDUCTION TO MAKE ONE EMOTIONAL AND PHYSICAL IN A BAD WAY! THE MATRIX FEEDS ON EMOTION! THE MATRIX FEEDS ON BAD EMOTIONS! THE OBJECTIVE IS TO GET YOU TO GENERATE DYNAMIC EMOTIONS! YOU MUST DETERMINE IF THE PERSON(S) YOU DEAL WITH HAVE CHANGED IN A BAD WAY. IF THEY HAVE CHANGED IN A BAD WAY AND YOU HAVE NOT CHANGED IN A BAD WAY THEN THEY HELD ON TO THE LIE WHILE YOU HELD ON TO THE TRUTH. TELL THEM THEY HAVE CHANGED AND GIVE THEM PHYSICAL EXAMPLES AND PERSONAL EXPERIENCES THAT THEY HAVE BEEN CHANGED BY THE SYSTEM. KEEP IN MIND THAT EVERYONE CHANGES SO YOU MAY FIND THAT THEY ACCUSE YOU OF CHANGING ALSO. TRUE LOVE IS THE ONLY UNCHANGED MATRIX. INTERESTING! KNOW HOW THE MANDELA EFFECT WORKS: THE EARTH IS ONE DIMENSION THAT DISPLAYS MULTIPLE ILLUSIONS. WE WILL ADDRESS SOME ABSOLUTE PHYSICAL THINGS WHICH ARE GOING ON WITH OR WITHOUT YOUR KNOWLEDGE. THERE'S SO MUCH TO COVER HERE. WE ARE ACTUALLY DOING PHYSICAL THINGS TO AID YOU IN ALL REALMS OF EXPERIENCE INCLUDING HELP FROM THE OTHER SIDE OF EARTH. PLEASE RESEARCH AND FIND OUT ALL YOU CAN AND ALWAYS QUESTION WHY FOR EVERYTHING. WHETHER YOU BELIEVE IN THE MANDELA EFFECT OR NOT, SOMETHING IS DEFINITELY GOING ON, THEREFORE EDUCATE AND FIND OUT THE TRUTH ABOUT THIS LIE WE CALL LIFE IN EARTH. TO THE ONE AND ONLY TRUE LOVE, WE ALL DESERVE TO BE FREE IN WILL, MIND AND BODY. |